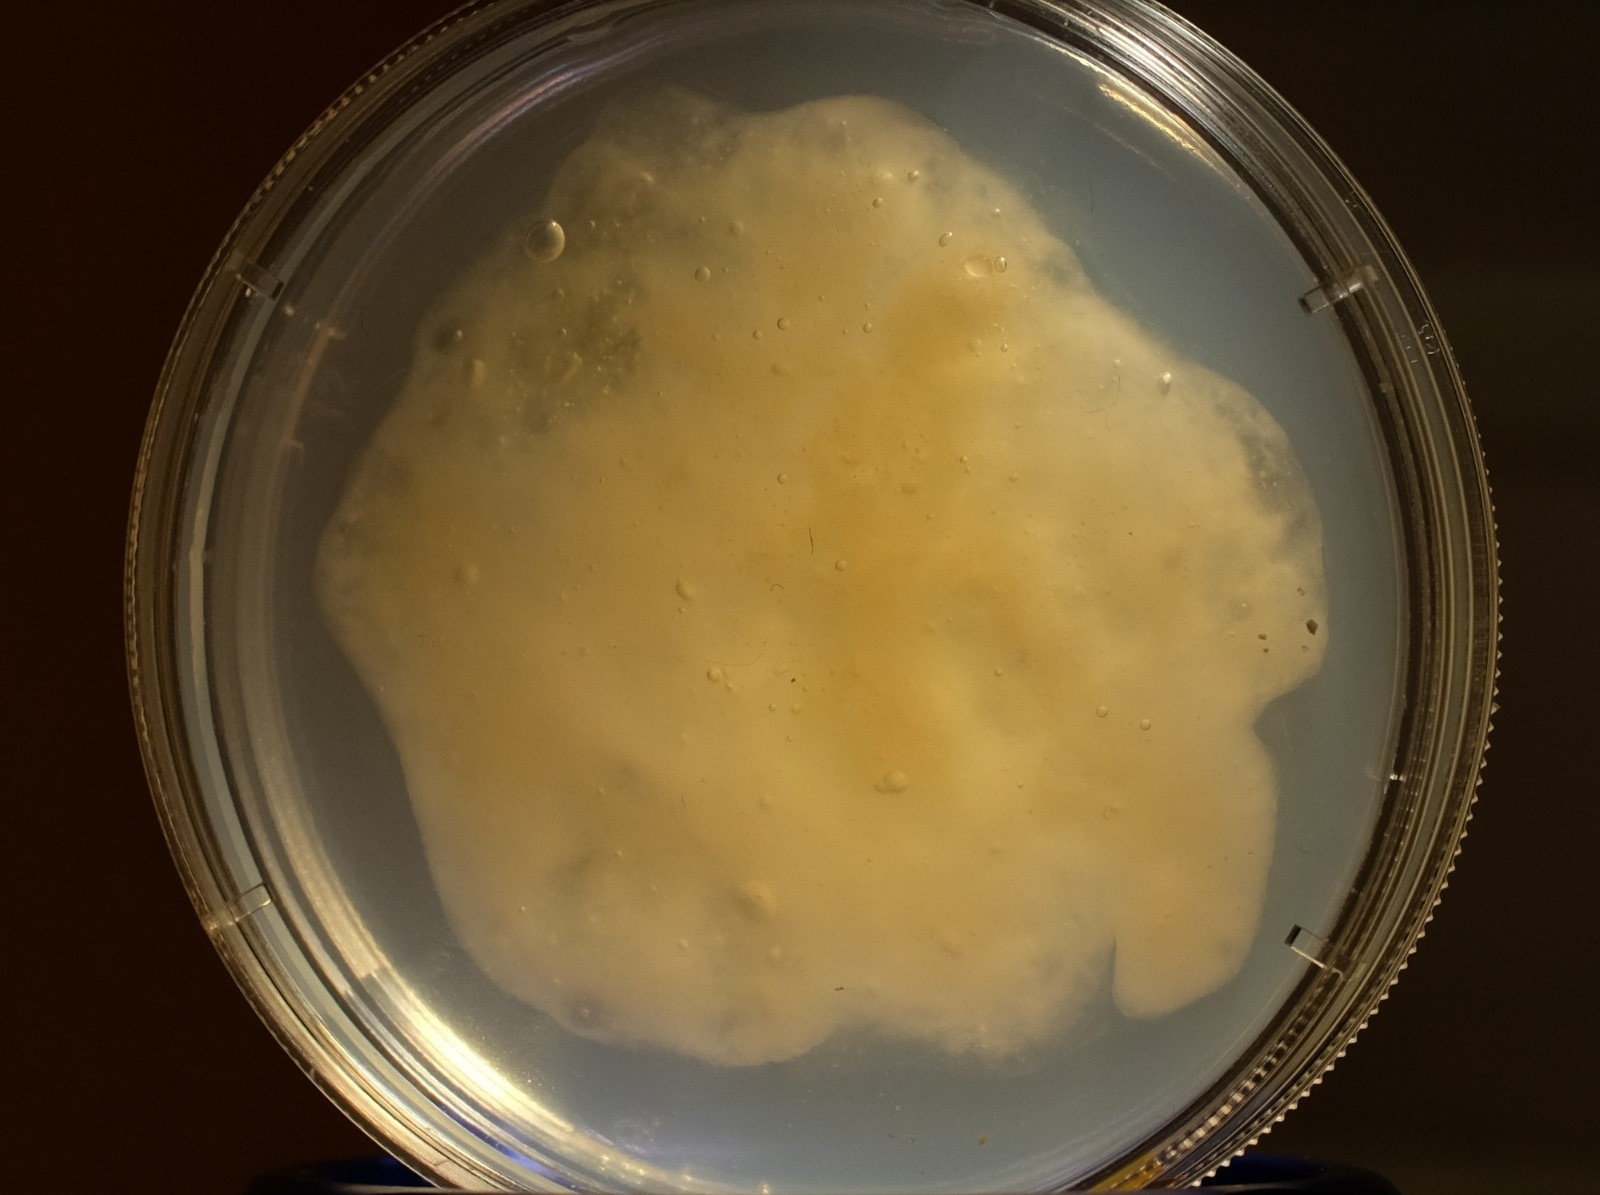
Пробиотики сельхозживотным теперь будут скармливать вместе с инновационным гелем

Синбиотические препараты, которые содержат сразу и пробиотики, и пребиотики, хорошо зарекомендовали себя в качестве средств для лечения животных. Их недостаток в том, что в кишечник они попадают не в полном объеме: часть полезных бактерий погибает в желудке.
Для того чтобы защитить бактерии и их метаболиты, ученые предложили пористый биоразлагаемый полимерный гель на основе хитозана.
«Он не просто позволяет попасть синбиотикам в кишечник, но и выступает в качестве субстрата — питательной среды для полезных бактерий», — пояснила руководитель проекта — директор научно-образовательного центра «Технологии биополимеров» НГТУ НЭТИ Виктория Бец. Эффективность биополимерной системы доказана в лабораторных условиях, уточнили в вузе.
В планах ученых НГТУ НЭТИ — создать комплексный препарат, в состав которого будут входить и бактерии, и вспомогательные вещества, а также провести эксперименты на сельскохозяйственных животных. Результатом должна стать кормовая добавка с «выраженным терапевтическим эффектом».
Как сообщало «ВиЖ», научно-исследовательский институт «Химрар» предложил метод энтерального введения лекарственных препаратов животным. Суть подхода заключается в добровольном поедании животными препарата в форме желе. Ученые разработали специальный состав такого «мармелада», чтобы он совмещался с лекарственными средствами.